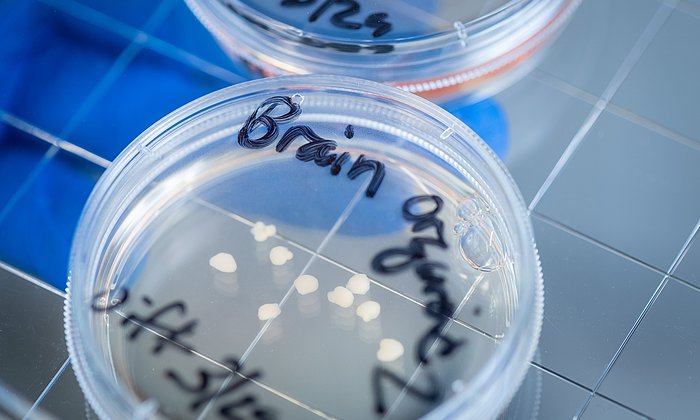
Gehirn-Organoide in einer Petrischale

Therapiewechsel kann im späten Stadium Verbesserung bringen
Parkinson: Neue Hoffnung für „austherapierte“ Betroffene

Parkinson ist nach Alzheimer weltweit die zweithäufigste neurodegenerative Erkrankung. Bislang ist die Erkrankung nicht heilbar, es können lediglich die Symptome behandelt werden. In einem frühen Stadium lassen sich die Beschwerden meist durch Tabletten lindern. Schreitet die Krankheit fort, reicht dies häufig nicht mehr aus.
Invasive Therapien als letzte Option
In diesem Fall kommen invasive Therapien zum Einsatz. Diese sind nicht nur mit hohen Kosten verbunden, sondern erfordern auch vergleichsweise schwere Eingriffe. Am längsten etabliert ist die Tiefe Hirnstimulation, bei der analog zu einem Herzschrittmacher Elektroden ins Gehirn implantiert werden. Neuer sind Pumptherapien: die automatisierte Gabe von Wirkstoffen über einen Schlauch direkt in den Darm oder über eine Nadel in die Bauchdecke. Doch auch diese fortgeschrittenen Therapien haben nicht immer den gewünschten Erfolg oder verlieren mit der Zeit ihre Wirksamkeit. Ist dies der Fall, scheuen Behandelnde und Erkrankte häufig davor zurück, eine andere invasive Therapie auszuprobieren oder die vorhandene Therapie mit einer zweiten zu kombinieren. Die Betroffenen gelten oft als austherapiert, was schwerwiegende Folgen für ihre Lebensqualität und Lebenserwartung haben kann.
Daten aus 22 Zentren: Therapiewechsel oft erfolgreich
Eine Studie eines Teams um Prof. Paul Lingor, Co-Leiter der Parkinson-Ambulanz am Klinikum rechts der Isar der TUM, gibt diesen Menschen jetzt neue Hoffnung. Die Forschenden haben Daten aus 22 Behandlungszentren des Kompetenznetzes Parkinson aus ganz Deutschland zusammengetragen, die einen Zeitraum von 2005 bis 2021 umfassen.
„Unter etwa 11.000 Menschen, die dort im Studienzeitraum mit fortgeschrittenen Therapien eingestellt wurden, konnten wir nur 116 identifizieren, bei denen eine fortgeschrittene Therapie ausgetauscht oder mit einer weiteren kombiniert wurde“, fasst Erstautor Dr. Dominik Pürner zusammen. Da auf einige Personen mehrere Therapiewechsel entfielen, konnten insgesamt 148 Fälle analysiert werden. Die Bewertung der Daten zeigte, dass die meisten der Eingriffe offenbar erfolgreich waren. Beispielsweise beschrieben Behandelnde und Betroffene eine subjektive Verbesserung der Beweglichkeit, die sich auch in objektiven Tests widerspiegelte.
Deutschlandweites Register geplant
„Die Menschen werden immer älter und deshalb werden wir uns immer häufiger die Frage stellen müssen, was wir für Betroffene tun können, wenn eine fortgeschrittene Therapie versagt“, sagt Paul Lingor. „Wir konnten zeigen: Die Erkrankten profitierten vom Therapiewechsel ungefähr so stark wie von der Einstellung auf die ursprüngliche Therapie – das ist ein enormer Nutzen.“ Bislang werden Therapiewechsel in Deutschland und anderen Ländern kaum in Studien erfasst. Aus Sicht der Forschenden verbessert die aktuelle Studie die Datenlage deutlich. Sie erlaube es unter anderem genauer anzuschauen, welche Gruppe von Betroffenen von welcher Strategie am meisten profitiere. Dies ermögliche, die Wahl des Therapiewechsels auf die vorherrschenden Beschwerden abzustimmen.
„Die Ergebnisse unserer Studie ermöglichen uns nun eine klare Handlungsempfehlung“, sagt Paul Lingor. „Wenn eine fortgeschrittene Therapie nicht oder nicht mehr die erwünschte Wirkung zeigt, sollte man einen Therapiewechsel erwägen. Diese Erkenntnis ist alles andere als trivial, denn es wäre auch möglich gewesen, dass im fortgeschrittenen Krankheitsstadium alle derzeit verfügbaren Therapien scheitern.“ Zukünftig möchten die Forschenden ein deutschlandweites Register anlegen, in das systematisch alle Parkinson-Patient:innen mit gerätegestützten Therapien aufgenommen werden sollen, um wissenschaftlich fundierte Leitlinien für die Kombination fortgeschrittener Therapien zu entwickeln.
D.Pürner, M. Hormozi, D. Weiß, M. T. Barbe, H. Jergas, T. Prell, E. Gülke, M. Pötter-Nerger, B. Falkenburger, L. Klingelhöfer, P. K. Gutsmiedl, B. Haslinger, A. M. Jochim, A. Wolff, N. Schröter, M. Rijntjes, C. van Riesen, U. Scheller, M. Wolz, A. Amouzandeh, G. Ebersbach, D. Gruber, Z. Kohl, W. Maetzler, S. Paschen, P. Pérez-González, V. Rozanski, J. Schwarz, M. Südmeyer, E. Torka, S. Wesbuer, S. Bornmann, A. Flöel, C. W. Ip, P. Krause, A. A. Kühn, I. Csoti, B. Herting, S. van de Loo, A. Ahammed Basheer, R. Liszka, W. H. Jost, J. Koschel, B. Haller, P. Lingor. „Nationwide Retrospective Analysis of Combinations of Advanced Therapies in Patients With Parkinson Disease“ Neurology (2023). DOI: 10.1212/WNL.0000000000207858
- Die Autor:innen danken den teilnehmenden Zentren aus dem Kompetenznetz Parkinson
- Prof. Paul Lingor ist Associate Investigator im Exzellenzcluster SyNergy.
Technische Universität München
Corporate Communications Center
- Larissa Tetsch / Paul Hellmich
- paul.hellmich@tum.de
- presse@tum.de
- Teamwebsite
Kontakte zum Artikel:
Prof. Dr. Paul Lingor
Technische Universität München
Klinikum rechts der Isar der TUM
Klinik und Poliklinik für Neurologie
Tel. +49 89 4140 8257
paul.lingor@tum.de
https://neurologie.mri.tum.de/